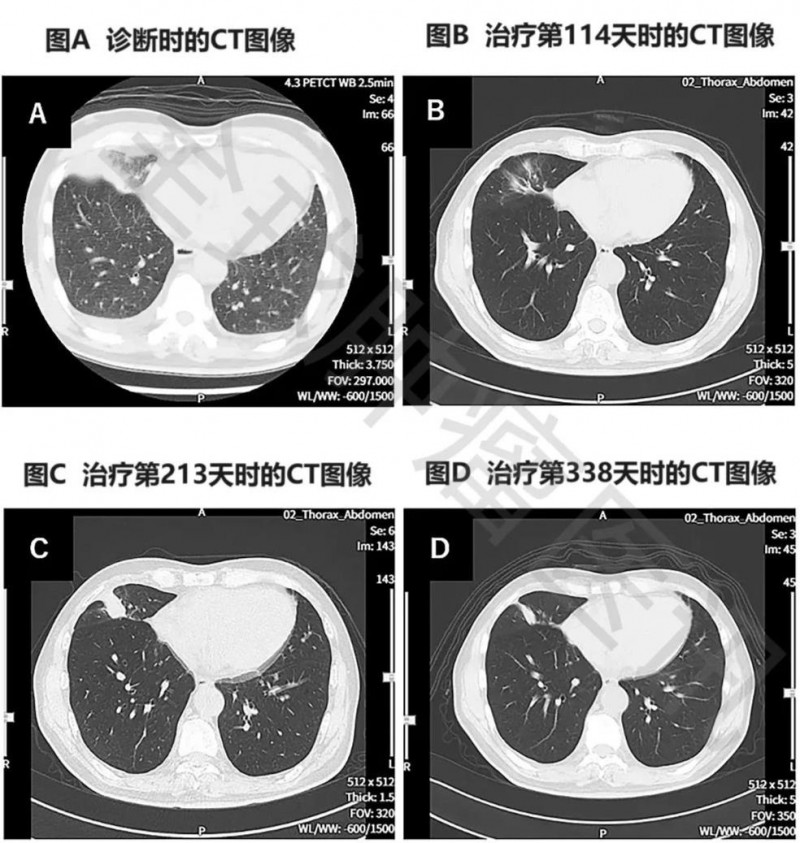
WT1-DC疫苗治疗肺癌的CT变化图

文章最后更新时间:2024-08-12 20:03:35,由春晓健康网负责审核发布,若内容或图片失效,请留言反馈!
WT1-DC疫苗为终末期肺癌患者带来曙光,无进展生存期超577天
WT1是一种常见的癌症抗原,在肺癌、乳腺癌、肝癌、胃癌、血液肿瘤等多种癌症中广泛表达,其在鳞状细胞肺癌中的表达率更是超过90%,日本常将其用作树突状细胞疫苗的通用抗原。
《Cureus》报道了一个“伴全身转移的终末期肺癌患者,经WT1-DC联合二线化疗后,获得长期显著缓解”的案例。本例患者为一名69岁的男性,确诊为右肺中叶IV期鳞状细胞癌,且伴双侧肾上腺转移、多发性骨转移、肝转移,此时已无法耐受手术及放疗等传统治法。入组接受WT1-DC+联合化疗(卡铂AUC6+紫杉醇)治疗后,结果显示如下:
1、无进展生存期(PFS):截至数据统计时止,该患者无进展生存期(PFS)已超577天。
2、癌胚抗原(CEA):癌胚抗原从诊断时的66.4,下降至3.0(治疗第121天)。
3、胸部CT显示:该患者在治疗第114天,复查胸部CT显示,肿瘤明显缩小(详见图2)。
图 治疗前后胸部CT图像对比
▲图源“Cureus”,版权归原作者所有,如无意中侵犯了知识产权,请联系我们删除
注:
①图A示:原发性右下肺癌,同时伴左右胸腔积液。
②图B示:原发病灶几乎消失。
③图C示:原发病灶存在一定程度的复发。
④图D示:原发性及复发性病灶均缩小。
4、全身PET-CT:治疗后第479天,复查全身PET-CT显示,除肝脏转移灶(直径1.7cm)、右肺转移灶(直径1.0cm)外,未见其他异常表现(详见下图)。
图 该患者治疗前后全身PET-CT对比

▲图源“Cureus”,版权归原作者所有,如无意中侵犯了知识产权,请联系我们删除
注:
图A:示右下肺原发肿瘤,伴多发性肝转移、多发性双侧肺内转移、多发性骨转移、双侧肾上腺转移。
图B:示肝脏可见1个小转移灶(直径约1.7cm),右肺见2个小转移灶(直径约1.0cm)。
上述结果表明,WT1-DC显著改善了患者的免疫状况,同时有助于维持长期的化疗效果,该例患者经WT1-DC联合辅助化疗后,癌症显著缩小,且幸运的未见复发及转移。





发表评论